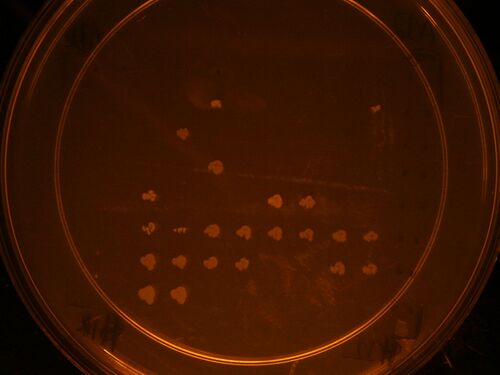

Berk2010-Christoph
TO DO
- Assemble the rest of the stage 4 parts
=Christoph Neyer 20:28, 5 September 2010 (EDT)
Choano assaying and Self lysis test starting Friday September 3rd:
- Friday:
- Transformed device 51 and 52 into strain 11 (payload strain, just GFP), also streaked out strain 11
- Saturday:
- Inoculated 10 mls (5,5) of TB each for 51, 52, and plain payload
- Inoculated 5 mls each of 75:25, 50:50, 25:75 ASW:LB, and choano media with 51 and 52.
- Inoculated 20 mls each (5,5,10) of plain LB with 51 and 52.
- Sunday:
- Observed growth in variety of medias:
- Choano media had no growth, mixtures of ASW and Lb had diminishing growth with increasing ASW.
- 25 ASW:75 LB looked indistinguishable from plain LB.
- All growth assessments were based on visual inspection of OD
- insert picture here
- Ran self-lysis assay:
- Tested self lysis of 51 and 52 in TB, LB and 50:50 ASM:LB, by inducing 2ml saturated cultures with 20ul arabinose.
- Tested self lysis of 51 and 52 in choano media by resuspeding a pellet of cells from 2ml of LB in 2ml of choano media.
- Insert pictures here of 1hr
- Insert pictures here of 2hrs
- Looks like everything worked except it was hard to tell for TB. Should rerun with TECAN to confirm.
- Ran time course choano assay for viewing the next day:
- Starting at 2:45 induced 1ml saturated cultures of 51, 52 and plain with 10 ul arabinose every 15mins for 90 mins.
- At 4:15 fed 1ul of the induced bacterial cultures to 1ml each of choanos in ASW.
- Also fed 1 ml of choanos with 10 ul of uninduced 51 in LB.
- Also fed 1ml each of choanos with 10 ul of 51 induced at 90,60,30.
- Observed growth in variety of medias:
Christoph Neyer 14:16, 12 August 2010 (EDT)
Creating reporter parts for assaying.
Goal is to create: Pcon.rbs.RFP.lifeact.GFP.term and PCON.rbs.GFP.lifeact.RFP.term
Starting parts:
- Bjh1881 in AK (rbs.RFP) Lefty
- jtk2541 in AK (rbs.ffGFP)
- Bjh2251 in CA {rbs_LifeAct_GDPPVAT>}.{<RFP!} Righty
- Bjh2252 in CA {rbs_LifeAct_GDPPVAT>}.{<GFP!} Righty
- Bca1152 in pBca1100 (Pcon)
- Bjh1906 in KA (term) Righty
Assembly steps:
- Un-methylate Bjh1881 in AK
- PCR Bca1152 and add to the front of Bjh2251 in CA
- PCR Bca1152 and add to the front of Bjh2252 in CA
- Manual 2ab
- Bca1152.Bjh2252 in CA + Bjh1881 in AK = Bca1152.Bjh2251.Bjh1881 in CK
- Bca1152.Bjh2251 in CA + jtk2541 in AK = Bca1152.Bjh2251.jtk2541 in CK
- Bca1152.Bjh2251.Bjh1881 in CK + Bjh1906 in KA = Bca1152.Bjh2251.Bjh1881.Bjh1906 in CA
- Bca1152.Bjh2251.jtk2541 in CK + Bjh1906 in KA = Bca1152.Bjh2251.jtk2541.Bjh1906 in CA
Assembly trees:
LifeactGFP-RFP LifeactRFP-GFP


Christoph Neyer 16:00, 9 August 2010 (EDT)
Cathups #4 from Gimli:
Gels:


Layout:
| ' | Lanes | ' | Part Name | Part size | Eco/xho Frags | eco/Xho Frags |
| iGEM10_140 in CA | 1,3,5,7,9,11,13,15 | iGEM10_140 | 1997 | 3269 | 1473 | |
| iGEM10_107 in CK | 2,4,6,8,10,12,14,16 | iGEM10_107 | 3169 | 4369 | 1473 | |
| iGEM10_109 in CK | 17,19,21,23,25,27,29,31 | iGEM10_109 | 3233 | 4433 | 1473 | |
| iGEM10_115 in CK | 18,20,24,26,28,30,32 | iGEM10_115 | 1966 | 3166 | 1473 | |
| iGEM10_116 in CK | 33,35,37,39,41,43,45,47 | iGEM10_116 | 1985 | 3185 | 1473 | |
| iGEM10_126 in CA | 34,36,38,40,42,44,46,48 | iGEM10_126 | 5981 | 7253 | 1473 |
Christoph Neyer 15:32, 6 August 2010 (EDT)
Catchups and adding terminators to stage 4 parts from Legolas:
Gel:

Layout:
| iGEM10_107 in CA | 1,3,5,7,9,11,13,15 | ' | iGEM10_107 | 3169 | 4441 | 1473 |
| iGEM10_109 in CA | 2,4,6,8,10,12,14,16 | iGEM10_109 | 3233 | 4505 | 1473 | |
| Ladder | ||||||
| iGEM10_112 in CA | 17,19,21,23,25,27,29,31 | iGEM10_112 | 2030 | 3302 | 1473 | |
| iGEM10_113 in CA | 18,20,24,26,28,30,32 | iGEM10_113 | 2049 | 3321 | 1473 | |
| Gel #2 | ||||||
| iGEM10_115 in CA | 1,3,5,7,9,11,13,15 | iGEM10_115 | 1966 | 3238 | 1473 | |
| iGEM10_116 in CA | 2,4,6,8,10,12,14,16 | iGEM10_116 | 1985 | 3257 | 1473 | |
| Ladder | ||||||
| iGEM10_130 in CA | 17,19,21,23,25,27,29,31 | iGEM10_130 | 4553 | 5825 | 1473 | |
| iGEM10_135 in CA | 18,20,24,26,28,30,32 | iGEM10_135 | 4952 | 6224 | 1473 |
Christoph Neyer 18:28, 5 August 2010 (EDT)
Miscelaneous Stage 4 catchups and jtk2541 in AK:
Gel:

Layout:
| ' | Lanes | Lanes | ' | ' | ' | ' |
| jtk2541 in AK | 1->8 | jtk2541 | 753 | 1953 | 1680 | |
| iGEM10_124 in CA | 9->16 | iGEM10_092 | 1989 | 3261 | 1473 | |
| iGEM10_134 in CA | 17->24 | iGEM10_110 | 3218 | 4490 | 1473 | |
| iGEM10_125 in CA | 25->28 | iGEM10_125 | 6603 | 7875 | 1473 |
Christoph Neyer 15:07, 4 August 2010 (EDT)
Stage 4 Round 3 and other catchups:
Gel 1:

Gel 2:

Part B:

Layout:
| Gel #1 | Lanes | Lanes | ' | ' | ' | ' |
| Bjh1906 in AK | 1,2,3,4 | Bjh1906 | 47 | 1247 | 1680 | |
| iGEM10_126 in CK | 5 | igem10_126 | 5981 | 7181 | 1473 | |
| Gel # 2 | ||||||
| iGEM10_092 in KA | 1,2 | 13,14 | iGEM10_092 | 1989 | 3261 | 1605 |
| iGEM10_110 in KA | 3,4 | 15,16 | iGEM10_110 | 3218 | 4490 | 1605 |
| iGEM10_125 in CA | 5,6 | 17,18 | iGEM10_125 | 6603 | 7875 | 1473 |
| iGEM10_133 in CA | 7,8 | 19,20 | iGEM10_133 | 3697 | 4969 | 1473 |
| iGEM10_136 in CA | 9,10 | 21,22 | iGEM10_136 | 4096 | 5368 | 1473 |
| iGEM10_138 in CA | 11,12 | 23,24 | iGEM10_138 | 4096 | 5368 | 1473 |
| Ladder | ||||||
| iGEM10_092 in KA | 25,26 | 37,38 | iGEM10_092 | 1989 | 3261 | 1605 |
| iGEM10_110 in KA | 27,28 | 39,40 | iGEM10_110 | 3218 | 4490 | 1605 |
| iGEM10_125 in CA | 29,30 | 41,42 | iGEM10_125 | 6603 | 7875 | 1473 |
| iGEM10_133 in CA | 31,32 | 43,44 | iGEM10_133 | 3697 | 4969 | 1473 |
| iGEM10_136 in CA | 33,34 | 45,46 | iGEM10_136 | 4096 | 5368 | 1473 |
| iGEM10_138 in CA | 35,36 | 47,48 | iGEM10_138 | 4096 | 5368 | 1473 |
Christoph Neyer 19:13, 2 August 2010 (EDT)
Ig114 has two mutations in it. One is a conservative mutation, but the other is not. we are E/B transferring jtk2541 in pBca9523 into pMLL6-KA.
jtk2541 is {rbs.ffGFP}.
We will then combine jtk2541 in KA with ig114 in CK to produce ig114.jtk2541 in CA. This will enable us to easily check whether the AraC-Pbad promoter is still working and inducible.
Christoph Neyer 19:07, 30 July 2010 (EDT)
Stage 4 Round 2 from Sauron:
Gels:
Part A:

Part B:

Layout:
| Stage 4 Round 2 from Sauron | ' | ' | ' | ' | ' | ' |
| Gel 1 | ||||||
| iGEM10_117 in CA | 1 and 2 | 17 and 18 | iGEM10_117 | 6246 | 7518 | 1473 |
| iGEM10_119 in CA | 3 and 4 | 19 and 20 | iGEM10_119 | 6645 | 7917 | 1473 |
| iGEM10_121 in CA | 5 and 6 | 21 and 22 | iGEM10_121 | 6645 | 7917 | 1473 |
| iGEM10_122 in CA | 7 and 8 | 23 and 24 | iGEM10_122 | 7459 | 8731 | 1473 |
| iGEM10_123 in CA | 9 and 10 | 25 and 26 | iGEM10_123 | 7459 | 8731 | 1473 |
| iGEM10_130 in CA | 11 and 12 | 27 and 28 | iGEM10_130 | 4553 | 5825 | 1473 |
| iGEM10_131 in CA | 13 and 14 | 29 and 30 | iGEM10_131 | 7060 | 8332 | 1473 |
| iGEM10_133 in CA | 15 and 16 | 31 and 32 | iGEM10_133 | 3697 | 4969 | 1473 |
| iGEM10_104 in KA | Manual | 33,35,37,39 | iGEM10_104 | 4869 | 6141 | 1605 |
| iGEM10_104 in KA | Robot | 34,36,38,40 | iGEM10_104 | 4869 | 6141 | 1605 |
| Gel 2 | ||||||
| iGEM10_136 in CA | 1 and 2 | 17 and 18 | iGEM10_136 | 4096 | 5368 | 1473 |
| iGEM10_137 in CA | 3 and 4 | 19 and 20 | iGEM10_137 | 4952 | 6224 | 1473 |
| iGEM10_138 in CA | 5 and 6 | 21 and 22 | iGEM10_138 | 4096 | 5368 | 1473 |
| iGEM10_113 in CA | 7 and 8 | 23 and 24 | iGEM10_113 | 2049 | 3321 | 1473 |
| iGEM10_127 in CK | 9 and 10 | 25 and 26 | iGEM10_127 | 4187 | 5387 | 1473 |
| iGEM10_128 in CK | 11 and 12 | 27 and 28 | iGEM10_128 | 5676 | 6876 | 1473 |
| iGEM10_129 in CK | 13 and 14 | 29 and 30 | iGEM10_129 | 5740 | 6940 | 1473 |
| iGEM10_135 in CA | 15 and 16 | 31 and 32 | iGEM10_135 | 4952 | 6224 | 1473 |
| iGEM10_106 in AK | Manual | 33,35,37,39 | iGEM10_106 | 3650 | 4850 | 1680 |
| iGEM10_106 in AK | Robot | 34,36,38,40 | iGEM10_106 | 3650 | 4850 | 1680 |
Christoph Neyer 18:42, 30 July 2010 (EDT)
Stage 4 repicks from Samwise:
Gels:
Part A:

Part B:

Layout:
| Stage 4 Round 1 Re-picks | Lanes | ' | Part Name | Part size | Eco/xho Frags | eco/Xho Frags |
| iGEM10_117 in CA | 1,3,5,7,9,11,13,15 | iGEM10_117 | 6246 | 7518 | 1473 | |
| iGEM10_127 in CK | 2,4,6,8,10,12,14,16 | iGEM10_127 | 4187 | 5387 | 1473 | |
| iGEM10_129 in CK | 17,19,21,23,25,27,29,31 | iGEM10_129 | 5740 | 6940 | 1473 | |
| iGEM10_133 in CA | 18,20,22,24,26,28,30,32 | iGEM10_133 | 3697 | 4969 | 1473 | |
| iGEM10_136 in CA | 33,35,37,39,41,43,45,47 | iGEM10_136 | 4096 | 5368 | 1473 | |
| iGEM10_138 in CA | 34,36,38,40,42,44,46,48 | iGEM10_138 | 4096 | 5368 | 1473 |
Christoph Neyer 14:52, 28 July 2010 (EDT)
Assembled Stage 4 Parts and some Stage 3 catchups.
Here is the RE map for parts from Pippin:
Gel:

Longer run time to better separate bands:

Layout:
| ' | ' | ' | ' | ' | ' | ' |
| Clones A and B are Gel #1 | Clones C and D are on Gel #2 | |||||
| Stage 4 parts + Stage 3 Catchups from Pippin | Lanes (Clones A and C) | Lanes (Clones B and D) | Part Name | Part size | Eco/xho Frags | eco/Xho Frags |
| iGEM10_117 in CA | 1 | 2 | iGEM10_117 | 6246 | 7518 | 1473 |
| iGEM10_118 in CA | 3 | 4 | iGEM10_118 | 4138 | 5410 | 1473 |
| iGEM10_119 in CA | 5 | 6 | iGEM10_119 | 6645 | 7917 | 1473 |
| iGEM10_120 in CA | 7 | 8 | iGEM10_120 | 4138 | 5410 | 1473 |
| iGEM10_121 in CA | 9 | 10 | iGEM10_121 | 6645 | 7917 | 1473 |
| iGEM10_132 in CA | 11 | 12 | iGEM10_132 | 3739 | 5011 | 1473 |
| iGEM10_133 in CA | 13 | 14 | iGEM10_133 | 3697 | 4969 | 1473 |
| iGEM10_136 in CA | 15 | 16 | iGEM10_136 | 4096 | 5368 | 1473 |
| iGEM10_088 in CA | 17 | 18 | iGEM10_088 | 1096 | 2368 | 1473 |
| iGEM10_088 in CA | 19 | 20 | iGEM10_088 | 1096 | 2368 | 1473 |
| iGEM10_127 in CK | 21 | 22 | iGEM10_127 | 4187 | 5387 | 1473 |
| iGEM10_128 in CK | 23 | 24 | iGEM10_128 | 5676 | 6876 | 1473 |
| iGEM10_129 in CK | 25 | 26 | iGEM10_129 | 5740 | 6940 | 1473 |
| iGEM10_138 in CA | 27 | 28 | iGEM10_138 | 4096 | 5368 | 1473 |
| iGEM10_139 in CA | 29 | 30 | iGEM10_139 | 3474 | 4746 | 1473 |
| iGEM10_103 in KA | 31 | 32 | iGEM10_103 | 5725 | 6997 | 1605 |
| iGEM10_103 in KA | 33 | 34 | iGEM10_103 | 5725 | 6997 | 1605 |
| iGEM10_104 in KA | 35 | 36 | iGEM10_104 | 4869 | 6141 | 1605 |
| iGEM10_110 in KA | 37 | 38 | iGEM10_110 | 3218 | 4490 | 1605 |
| iGEM10_110 in KA | 39 | 40 | iGEM10_110 | 3218 | 4490 | 1605 |
Christoph Neyer 14:22, 26 July 2010 (EDT)
Assembled Stage 3 parts and some stage 2 catchups.
Here is the RE map for the parts from Gandalf:
Gel:

Layout:
| ' | Clones A and B are Gel #1 | Clones C and D are on Gel #2 | ' | ' | ' | ' |
| Stage 3 parts + Stage 2 Cathups from Gandalf | Lanes (Clones A and C) | Lanes (Clones B and D) | Part Name | Part size | Eco/xho Frags | eco/Xho Frags |
| iGEM10_105 in CA | 1 | 2 | iGEM10_105 | 2331 | 3603 | 1473 |
| iGEM10_107 in CA | 3 | 4 | iGEM10_107 | 3169 | 4441 | 1473 |
| iGEM10_109 in CA | 5 | 6 | iGEM10_109 | 3233 | 4505 | 1473 |
| iGEM10_088 in AC | 7 | 8 | iGEM10_088 | 1096 | 2162 | 1679 |
| iGEM10_084 in KC | 9 | 10 | iGEM10_084 | 2154 | 3220 | 1605 |
| iGEM10_101 in KA | 11 | 12 | iGEM10_101 | 4911 | 6183 | 1605 |
| iGEM10_102 in KA | 13 | 14 | iGEM10_102 | 2404 | 3676 | 1605 |
| iGEM10_108 in AK | 15 | 16 | iGEM10_108 | 1018 | 2218 | 1680 |
| iGEM10_111 in KA | 17 | 18 | iGEM10_111 | 2362 | 3634 | 1605 |
| iGEM10_114 in KA | 19 | 20 | iGEM10_114 | 1740 | 3012 | 1605 |
| iGEM10_112 in CA | 21 | 22 | iGEM10_112 | 2030 | 3302 | 1473 |
| iGEM10_113 in CA | 23 | 24 | iGEM10_113 | 2049 | 3321 | 1473 |
| iGEM10_115 in CA | 25 | 26 | iGEM10_115 | 1966 | 3238 | 1473 |
| iGEM10_116 in CA | 27 | 28 | iGEM10_116 | 1985 | 3257 | 1473 |
| iGEM10_085 in CA | 29 | 30 | iGEM10_085 | 3571 | 4843 | 1473 |
| iGEM10_087 in CA | 31 | 32 | iGEM10_087 | 3564 | 4836 | 1473 |
| iGEM10_097 in CA | 33 | 34 | iGEM10_097 | 2278 | 3550 | 1473 |
Christoph Neyer 15:47, 22 July 2010 (EDT)
Did:
- Miniprep Stage 1 parts
- Miniprep Stage 2 parts
- Pick colonies for iGEM10_064 in KC and iGEM10_65 in CK, and sbb18 in KA.
Christoph Neyer 16:42, 22 July 2010 (EDT)
Stage 1 Retransformations from Marley RE map:
Gel Part A:

Gel Part B:

Small Gel:

Layout:
| Stage 1 Re-transforms From Marley | Lanes (Clones A) | Lanes (Clones B) | Part Name | Part size | Eco/xho Frags | eco/Xho Frags |
| iGEM10_077 in CA | 1 | 2 | iGEM10_077 | 1879 | 3151 | 1473 |
| iGEM10_078 in CA | 3 | 4 | iGEM10_078 | 1522 | 2794 | 1473 |
| iGEM10_079 in CA | 5 | 6 | iGEM10_079 | 1117 | 2389 | 1473 |
| iGEM10_056 in AC | 7 | 8 | iGEM10_056 | 82 | 1148 | 1679 |
| iGEM10_061 in CA | 9 | 10 | iGEM10_061 | 1064 | 2336 | 1473 |
| iGEM10_063 in CA | 11 | 12 | iGEM10_063 | 1057 | 2329 | 1473 |
| iGEM10_066 in CA | 13 | 14 | iGEM10_066 | 80 | 1352 | 1473 |
| iGEM10_062 in AC | 15 | 16 | iGEM10_062 | 279 | 1345 | 1679 |
| iGEM10_054 in CA | 17 | 18 | iGEM10_054 | 1335 | 2607 | 1473 |
| iGEM10_067 in CA | 19 | 20 | iGEM10_067 | 157 | 1429 | 1473 |
| iGEM10_068 in AK | 21 | 22 | iGEM10_068 | 771 | 1971 | 1680 |
| iGEM10_055 in KA | 23 | 24 | iGEM10_055 | 1464 | 2736 | 1605 |
| iGEM10_055 in KA | 25 | 26 | iGEM10_055 | 1464 | 2736 | 1605 |
| iGEM10_065 in CK | 27 | 28 | iGEM10_065 | 2554 | 3754 | 1473 |
| iGEM10_057 in CK | 29 | 30 | iGEM10_057 | 858 | 2058 | 1473 |
| Ladder | Ladder | |||||
| iGEM10_071 in KC | 31 | 32 | iGEM10_071 | 1909 | 2975 | 1605 |
| iGEM10_072 in KC | 33 | 34 | iGEM10_072 | 697 | 1763 | 1605 |
| iGEM10_061 in CK | 35 | 36 | iGEM10_061 | 1064 | 2264 | 1473 |
| iGEM10_063 in CK | 37 | 38 | iGEM10_063 | 1057 | 2257 | 1473 |
| iGEM10_073 in CK | 39 | 40 | iGEM10_073 | 996 | 2196 | 1473 |
| iGEM10_074 in CK | 41 | 42 | iGEM10_074 | 490 | 1690 | 1473 |
| EMPTY | 43 | 44 | EMPTY | #N/A | #N/A | #N/A |
| iGEM10_054 in CK | 45 | 46 | iGEM10_054 | 1335 | 2535 | 1473 |
| Small gel | ||||||
| iGEM10_076 in AK | 1 | 2 | iGEM10_076 | 1878 | 3078 | 1680 |
| iGEM10_057 in CA | 3 | 4 | iGEM10_057 | 858 | 2130 | 1473 |
| iGEM10_060 in AC | 5 | 6 | iGEM10_060 | 366 | 1432 | 1679 |
| iGEM10_075 in CK | 7 | 8 | iGEM10_075 | 490 | 1690 | 1473 |
| iGEM10_065 in CK | 9 | 10 | iGEM10_065 | 2554 | 3754 | 1473 |
Christoph Neyer 15:46, 22 July 2010 (EDT)
Stage 2 Parts RE map from Frodo:
Gel:

Layout:
| Stage 2 parts from Frodo | Clones A and B are Gel #1 | Clones C and D are on Gel #2 | ' | ' | ' | ' |
| Lanes (Clones A and C) | Lanes (Clones B and D) | Part Name | Part size | Eco/xho Frags | eco/Xho Frags | |
| iGEM10_080 in KC | 1 | 2 | iGEM10_080 | 1546 | 2612 | 1605 |
| iGEM10_082 in CK | 3 | 4 | iGEM10_082 | 1734 | 2934 | 1473 |
| iGEM10_083 in CK | 5 | 6 | iGEM10_083 | 1734 | 2934 | 1473 |
| iGEM10_084 in KC | 7 | 8 | iGEM10_084 | 2154 | 3220 | 1605 |
| iGEM10_086 in KC | 9 | 10 | iGEM10_086 | 1305 | 2371 | 1605 |
| iGEM10_081 in CA | 11 | 12 | iGEM10_081 | 3365 | 4637 | 1473 |
| iGEM10_093 in CA | 13 | 14 | iGEM10_093 | 1043 | 2315 | 1473 |
| iGEM10_094 in CA | 15 | 16 | iGEM10_094 | 2278 | 3550 | 1473 |
| iGEM10_095 in CA | 17 | 18 | iGEM10_095 | 1954 | 3226 | 1473 |
| Ladder | Ladder | #N/A | #N/A | #N/A | ||
| iGEM10_096 in CA | 19 | 20 | iGEM10_096 | 1516 | 2788 | 1473 |
| iGEM10_098 in CA | 21 | 22 | iGEM10_098 | 1954 | 3226 | 1473 |
| iGEM10_099 in CA | 23 | 24 | iGEM10_099 | 1516 | 2788 | 1473 |
| iGEM10_100 in CA | 25 | 26 | iGEM10_100 | 1087 | 2359 | 1473 |
| iGEM10_089 in KA | 27 | 28 | iGEM10_089 | 1925 | 3197 | 1605 |
| iGEM10_091 in KA | 29 | 30 | iGEM10_091 | 1898 | 3170 | 1605 |
| iGEM10_092 in KA | 31 | 32 | iGEM10_092 | 1989 | 3261 | 1605 |
| iGEM10_090 in CK | 33 | 34 | iGEM10_090 | 928 | 2128 | 1473 |
Christoph Neyer 19:08, 21 July 2010 (EDT)
Stage 1 parts grew up last night. Most things grew. Picked 4 colonies for most of the parts from stage 2 to miniprep tomorrow.
Yesterday we plated all the stage 1 parts and grew them up on plates. Today we picked 2 colonies for each to miniprep tomorrow.
Reassembled igem10_064 in KC and retransformed igem10_065 CK (Also picked colonies from an old plate).
Also retransformed Sbb18 in KA Lefty because miniprep is weak.
Christoph Neyer 15:38, 20 July 2010 (EDT)
RE map of Ophelia columns 1-3:

Layout:
| ' | Lane # | Part Name | Part size | Eco/xho Frags | eco/Xho Frags |
| iGEM10_076 in AK | 1 | iGEM10_076 | 1878 | 3078 | 1680 |
| iGEM10_077 in CA | 2 | iGEM10_077 | 1879 | 3151 | 1473 |
| iGEM10_078 in CA | 3 | iGEM10_078 | 1522 | 2794 | 1473 |
| iGEM10_079 in CA | 4 | iGEM10_079 | 1117 | 2389 | 1473 |
| iGEM10_055 in KA | 5 | iGEM10_055 | 1464 | 2736 | 1605 |
| iGEM10_068 in AK | 6 | iGEM10_068 | 771 | 1971 | 1680 |
| iGEM10_065 in CK | 7 | iGEM10_065 | 2554 | 3754 | 1473 |
| iGEM10_056 in AC | 8 | iGEM10_056 | 82 | 1148 | 1679 |
| iGEM10_057 in CA | 9 | iGEM10_057 | 858 | 2130 | 1473 |
| iGEM10_060 in AC | 10 | iGEM10_060 | 366 | 1432 | 1679 |
| iGEM10_061 in CA | 11 | iGEM10_061 | 1064 | 2336 | 1473 |
| iGEM10_063 in CA | 12 | iGEM10_063 | 1057 | 2329 | 1473 |
| iGEM10_057 in CK | 13 | iGEM10_057 | 858 | 2058 | 1473 |
| iGEM10_061 in CK | 14 | iGEM10_061 | 1064 | 2264 | 1473 |
| iGEM10_063 in CK | 15 | iGEM10_063 | 1057 | 2257 | 1473 |
| iGEM10_071 in KC | 16 | iGEM10_071 | 1909 | 2975 | 1605 |
| iGEM10_072 in KC | 17 | iGEM10_072 | 697 | 1763 | 1605 |
| iGEM10_073 in CK | 18 | iGEM10_073 | 996 | 2196 | 1473 |
| iGEM10_074 in CK | 19 | iGEM10_074 | 490 | 1690 | 1473 |
| iGEM10_075 in CK | 20 | iGEM10_075 | 490 | 1690 | 1473 |
| iGEM10_055 in KA | 21 | iGEM10_055 | 1464 | 2736 | 1605 |
| iGEM10_054 in CA | 22 | iGEM10_054 | 1335 | 2607 | 1473 |
| iGEM10_067 in CA | 23 | iGEM10_067 | 157 | 1429 | 1473 |
| iGEM10_066 in CA | 24 | iGEM10_066 | 80 | 1352 | 1473 |
Christoph Neyer 15:47, 19 July 2010 (EDT)
RE mapping of Stage 1 Catchups from Guildenstern Columns 5+7:
Gel:
 Layout:
Layout:
| ' | ' | ' | Part Name | Part size | Eco/xho Frags | eco/Xho Frags |
| iGEM10_062 in AC | 1,2 | 3,4 | iGEM10_062 | 279 | 1345 | 1679 |
| iGEM10_079 in CA | 5 | 6 | iGEM10_079 | 1117 | 2389 | 1473 |
| iGEM10_065 in CK | 7 | 8 | iGEM10_065 | 2554 | 3754 | 1473 |
Christoph Neyer 19:57, 18 July 2010 (EDT)
RE mapping Stage 1 Parts from Rosencrantz and Guildenstern:
- Gel # 1 (Clones A+B from Rosencrantz):
- Gel # 2 (Clones A+B from Rosencrantz):
- Gel # 3 (Guildenstern Columns 1+3):
Layout:
| Clones A and B are Gel #1 | ' | ' | ' | ' | ' | ' |
| Clones C and D are on Gel #2 | ||||||
| Lanes Clone A,C | Lanes Clone B,D | Part Name | Part size | Eco/xho Frags | eco/Xho Frags | |
| iGEM10_076 in AK | 1 | 2 | iGEM10_076 | 1878 | 3078 | 1680 |
| iGEM10_077 in CA | 3 | 4 | iGEM10_077 | 1879 | 3151 | 1473 |
| iGEM10_078 in CA | 5 | 6 | iGEM10_078 | 1522 | 2794 | 1473 |
| iGEM10_079 in CA | 7 | 8 | iGEM10_079 | 1117 | 2389 | 1473 |
| iGEM10_055 in KA | 9 | 10 | iGEM10_055 | 1464 | 2736 | 1605 |
| iGEM10_068 in AK | 11 | 12 | iGEM10_068 | 771 | 1971 | 1680 |
| iGEM10_064 in KC | 13 | 14 | iGEM10_064 | 996 | 2062 | 1605 |
| iGEM10_065 in CK | 15 | 16 | iGEM10_065 | 2554 | 3754 | 1473 |
| iGEM10_056 in AC | 17 | 18 | iGEM10_056 | 82 | 1148 | 1679 |
| iGEM10_057 in CA | 19 | 20 | iGEM10_057 | 858 | 2130 | 1473 |
| iGEM10_060 in AC | 21 | 22 | iGEM10_060 | 366 | 1432 | 1679 |
| iGEM10_062 in AC | 23 | 24 | iGEM10_062 | 279 | 1345 | 1679 |
| iGEM10_066 in CA | 25 | 26 | iGEM10_066 | 80 | 1352 | 1473 |
| iGEM10_061 in CA | 27 | 28 | iGEM10_061 | 1064 | 2336 | 1473 |
| iGEM10_063 in CA | 29 | 30 | iGEM10_063 | 1057 | 2329 | 1473 |
| iGEM10_054 in CK | 31 | 32 | iGEM10_054 | 1335 | 2535 | 1473 |
| iGEM10_057 in CK | 33 | 34 | iGEM10_057 | 858 | 2058 | 1473 |
| iGEM10_061 in CK | 35 | 36 | iGEM10_061 | 1064 | 2264 | 1473 |
| iGEM10_063 in CK | 37 | 38 | iGEM10_063 | 1057 | 2257 | 1473 |
| iGEM10_071 in KC | 39 | 40 | iGEM10_071 | 1909 | 2975 | 1605 |
| iGEM10_072 in KC | 41 | 42 | iGEM10_072 | 697 | 1763 | 1605 |
| iGEM10_073 in CK | 43 | 44 | iGEM10_073 | 996 | 2196 | 1473 |
| iGEM10_074 in CK | 45 | 46 | iGEM10_074 | 490 | 1690 | 1473 |
| iGEM10_075 in CK | 47 | 48 | iGEM10_075 | 490 | 1690 | 1473 |
| Small Gel | ||||||
| iGEM10_055 in KA | 1 | 2 | iGEM10_055 | 1464 | 2736 | 1605 |
| iGEM10_054 in CA | 1,2 | 3,4 | iGEM10_054 | 1335 | 2607 | 1473 |
| iGEM10_067 in CA | 5,6 | 7,8 | iGEM10_067 | 157 | 1429 | 1473 |
| iGEM10_066 in CA | 9,10 | 11,12 | iGEM10_066 | 80 | 1352 | 1473 |
Christoph Neyer 22:00, 14 July 2010 (EDT)
RE map of KA transfers:

Layout:
| ' | Lane | Lane | part | Part size | Eco/xho Frags | eco/Xho Frags |
| sbb19 in KA | 1 | 2 | sbb19 | 597 | 1869 | 1605 |
| sbb18 in KA | 3 | 4 | sbb18 | 399 | 1671 | 1605 |
| sbb10 in KA | 5 | 6 | sbb10 | 1026 | 2298 | 1605 |
| sbb42 in KA | 7 | 8 | sbb42 | 91 | 1363 | 1605 |
| sbb04 in KA | 9 | 10 | sbb04 | 1788 | 3060 | 1605 |
| sbb06 in KA | 11 | 12 | sbb06 | 241 | 1513 | 1605 |
| sbb04 in KA | 13 | 14 | sbb04 | 1788 | 3060 | 1605 |
| Bjh2245 in KA | 15 | 16 | Bjh2245 | 97 | 1369 | 1605 |
| Bjh1906 in KA | 17 | 18 | Bjh1906 | 47 | 1319 | 1605 |
| sbb19 in KA | 19 | 20 | sbb19 | 597 | 1869 | 1605 |
| sbb12 in KA | 21 | 22 | sbb12 | 234 | 1506 | 1605 |
| sbb09 in KA | 23 | 24 | sbb09 | 35 | 1307 | 1605 |
| sbb10 in KA | 25 | 26 | sbb10 | 1026 | 2298 | 1605 |
| sbb42 in KA | 27 | 28 | sbb42 | 91 | 1363 | 1605 |
| Bjh2294 in KA | 29 | 30 | Bjh2294 | 2507 | 3779 | 1605 |
| sbb07 in KA | 31 | 32 | sbb07 | 1431 | 2703 | 1605 |
Christoph Neyer 16:08, 14 July 2010 (EDT)
Checking some of the parts from Oliver twist:

Layout:
| Lane # | ' | Plate | Location | part | Part size | Eco/xho Frags | eco/Xho Frags |
| 1 | sbb15 in AC | Future | A1 | sbb15 | 90 | 1156 | 1679 |
| 3 | sbb43 in AK | Future | A4 | sbb43 | 100 | 1300 | 1680 |
| 5 | Bjh1906 in AK | Future | B4 | Bjh1906 | 47 | 1247 | 1680 |
| 7 | sbb13 in AC | Future | B7 | sbb13 | 1818 | 2884 | 1679 |
| 9 | Bjh2294 in AK | Future | F10 | Bjh2294 | 2507 | 3707 | 1680 |
| 11 | Bjh1858 in CA | Future | A12 | Bjh1858 | 33 | 1305 | 1473 |
| 2 | sbb15 in AC | Tiny Tim | A1 | sbb15 | 90 | 1156 | 1679 |
| 4 | sbb43 in AK | Tube C | na | sbb43 | 100 | 1300 | 1680 |
| 6 | Bjh1906 in AK | Cat | A1 | Bjh1906 | 47 | 1247 | 1680 |
| 8 | sbb13 in AC | Tiny Tim | C7 | sbb13 | 1818 | 2884 | 1679 |
| 10 | Bjh2294 in AK | Cat | A5 | Bjh2294 | 2507 | 3707 | 1680 |
| 12 | Bjh1858 in CA | Scrooge | A12 | Bjh1858 | 33 | 1305 | 1473 |
Christoph Neyer 18:05, 13 July 2010 (EDT)
Rechecked pMLL7 and pMLL4 for methylated parts:

Layout:
| Lane # | Part in vector | opposite vector | Part | Vector | Part | Location in Tiny Tim | Enzymes | Expected bands | Expected bands | Wrong Bands | Wrong Bands |
| 1 | Bjh2294 in AK | pMLL6-KA | Bjh2294 | pMLL7-AK | Bjh2294 | Get from Chesire cat A 5 | EcoRI/Bgl1 | 4554 | 830 | 3479 | 1905 |
| 2 | Bjh1906 in CA | pMLL4-AC | Bjh1906 | pMLL9-CA | Bjh1906 | A6 | EcoRI/Bgl1 | 1773 | 1019 | 1962 | 830 |
| 3 | sbb06 in AK | pMLL6-KA | sbb06 | pMLL7-AK | sbb06 | G10 | EcoRI/Bgl1 | 2288 | 830 | 1905 | 1213 |
| 4 | sbb44 in CA | pMLL4-AC | sbb44 | pMLL9-CA | sbb44 | C6 | EcoRI/Bgl1 | 1795 | 1773 | 2738 | 830 |
Christoph Neyer 23:23, 12 July 2010 (EDT)
Stage 1 Round 3 RE map of minipreps for parts not involving KA inputs. Located on Oliver Twist.
Gel Part A:

Gel Part B:

Layout:
| RE Map of Oliver Twist | Part A Lane # | Part B Lane # | Part C Lane # | Part D Lane # | Part Name | Part size | Lefty size | Righty Size | Eco/xho Frags | eco/Xho Frags | Analysis A | Analysis B | Re-run/re-pick? |
| iGEM10_076 in AK | 1 | 2 | 23 | 24 | iGEM10_076 | 1878 | 1845 | 33 | 3078 | 1680 | |||
| iGEM10_055 in KA | 3 | 4 | 25 | 26 | iGEM10_055 | 1464 | 1431 | 33 | 2736 | 1605 | |||
| iGEM10_068 in AK | 5 | 6 | 27 | 28 | iGEM10_068 | 771 | 681 | 90 | 1971 | 1680 | |||
| iGEM10_065 in CK | 7 | 8 | 29 | 30 | iGEM10_065 | 2554 | 47 | 2507 | 3754 | 1473 | |||
| iGEM10_073 in CK | 9 | 10 | 31 | 32 | iGEM10_073 | 996 | 399 | 597 | 2196 | 1473 | |||
| iGEM10_054 in CK | 11 | 12 | 33 | 34 | iGEM10_054 | 1335 | 1244 | 91 | 2535 | 1473 | |||
| iGEM10_057 in CK | 13 | 14 | 35 | 36 | iGEM10_057 | 858 | 823 | 35 | 2058 | 1473 | |||
| iGEM10_061 in CK | 15 | 16 | 37 | 38 | iGEM10_061 | 1064 | 823 | 241 | 2264 | 1473 | |||
| iGEM10_063 in CK | 17 | 18 | 39 | 40 | iGEM10_063 | 1057 | 823 | 234 | 2257 | 1473 | |||
| iGEM10_074 in CK | 19 | 20 | 41 | 42 | iGEM10_074 | 490 | 91 | 399 | 1690 | 1473 | |||
| iGEM10_055 in KA | 21 | 22 | 43 | 44 | iGEM10_055 | 1464 | 1431 | 33 | 2736 | 1605 |
Christoph Neyer 19:24, 12 July 2010 (EDT)
Col PCR Stage 1 Round 3:
Part A:

Part B:

Part C:

Christoph Neyer 16:41, 12 July 2010 (EDT)
Checking Vector Backbones Gel:

| Lane # | Part in vector | Vector + Ebid | Location in Romeo | Enzymes | Expected bands | Expected bands | Wrong Bands | Wrong Bands |
| 1 | sbb14 in AC | 4 + 17 | E8 | EcoRI/Bgl1 | 3760 | 830 | 2817 | 1773 |
| 2 | ig114 in CK | 5 + 8 | D5 | EcoRI/ScaI | 3221 | 694 | 2146 | 1769 |
| 3 | sbb06 in KA | 6 + 5 | F1 | EcoRI/Bgl1 | 1905 | 1213 | 2288 | 830 |
| 4 | sbb17 in AK | 7 + 14 | E4 | EcoRI/Bgl1 | 2446 | 830 | 1905 | 1371 |
| 5 | sbb07 in KC | 8 + 4 | F6 | EcoRI/ScaI | 2333 | 1769 | 3408 | 694 |
| 6 | sbb18 in CA | 9 + 13 | G9 | EcoRI/Bgl1 | 1773 | 1371 | 2314 | 830 |
Christoph Neyer 21:25, 7 July 2010 (EDT)
Did colony PCR of Stage 1 Round 2assembly parts.
Layout for both gels:
| ' | Lane | ' | ' |
| Clone 1,3 | Clone 2,4 | Expected Band | |
| iGEM10_076 in AK | 1 | 2 | 2078 |
| iGEM10_055 in KA | 3 | 4 | 1664 |
| iGEM10_068 in AK | 5 | 6 | 971 |
| iGEM10_064 in KC | 7 | 8 | 1196 |
| iGEM10_065 in CK | 9 | 10 | 2754 |
| iGEM10_056 in AC | 11 | 12 | 282 |
| iGEM10_057 in CA | 13 | 14 | 1058 |
| iGEM10_060 in AC | 15 | 16 | 566 |
| iGEM10_062 in AC | 17 | 18 | 479 |
| iGEM10_066 in CA | 19 | 20 | 280 |
| iGEM10_061 in CA | 21 | 22 | 1264 |
| iGEM10_063 in CA | 23 | 24 | 1257 |
| iGEM10_054 in CK | 25 | 26 | 1535 |
| iGEM10_057 in CK | 27 | 28 | 1058 |
| iGEM10_061 in CK | 29 | 30 | 1264 |
| iGEM10_063 in CK | 31 | 32 | 1257 |
| iGEM10_071 in KC | 33 | 34 | 2109 |
| iGEM10_072 in KC | 35 | 36 | 897 |
| iGEM10_073 in CK | 37 | 38 | 1196 |
| iGEM10_074 in CK | 39 | 40 | 690 |
| iGEM10_075 in CK | 41 | 42 | 690 |
| iGEM10_055 in KA | 43 | 44 | 1664 |
| iGEM10_054 in CA | 45 | 46 | 1535 |
| iGEM10_067 in CA | 47 | 48 | 357 |
Christoph Neyer 19:35, 7 July 2010 (EDT)
Christoph Neyer 21:47, 6 July 2010 (EDT)
Did round 1 of 2ab assembly today.
Here's the gel for ColPCR of 7 with 10 into Lefty strain.

Christoph Neyer 16:31, 5 July 2010 (EDT)
Restriction map of Methylated Parts for stage 0 reruns:

Layout:
| Re-runs | ' | ' | ' | ' | ' | ' |
| sbb43 in AK | 1 | 2 | sbb43 | 100 | 1300 | 1680 |
| ig114 in CA | 3 | 4 | ig114 | 1244 | 2516 | 1473 |
| Bjh1858 in CK | 5 | 6 | Bjh1858 | 33 | 1233 | 1473 |
| sbb07 in KA | 7 | 8 | sbb07 | 1431 | 2703 | 1605 |
| sbb20 in AK | 9 | 10 | sbb20 | 597 | 1797 | 1680 |
Christoph Neyer 20:41, 2 July 2010 (EDT)
Restriction maps of Methylated Parts for Stage 0:
| ' | Part A Lane # | Part B Lane # | Part Name | Part size | Eco/xho Frags | eco/Xho Frags |
| sbb15 in AC | 1 | 2 | sbb15 | 90 | 1156 | 1679 |
| sbb14 in AC | 3 | 4 | sbb14 | 1845 | 2911 | 1679 |
| Bjh1882 in AC | 5 | 6 | Bjh1882 | 681 | 1747 | 1679 |
| sbb19 in KA | 7 | 8 | sbb19 | 597 | 1869 | 1605 |
| sbb18 in KA | 9 | 10 | sbb18 | 399 | 1671 | 1605 |
| sbb10 in KA | 11 | 12 | sbb10 | 1026 | 2298 | 1605 |
| sbb42 in KA | 13 | 14 | sbb42 | 91 | 1363 | 1605 |
| sbb04 in KA | 15 | 16 | sbb04 | 1788 | 3060 | 1605 |
| sbb42 in CK | 17 | 18 | sbb42 | 91 | 1291 | 1473 |
| sbb37 in CK | 19 | 20 | sbb37 | 41 | 1241 | 1473 |
| Bjh1858 in CK | 21 | 22 | Bjh1858 | 33 | 1233 | 1473 |
| ig114 in CK | 23 | 24 | ig114 | 1244 | 2444 | 1473 |
| Bca1091 in CK | 25 | 26 | Bca1091 | 60 | 1260 | 1473 |
| sbb44 in CK | 27 | 28 | sbb44 | 823 | 2023 | 1473 |
| sbb43 in AK | 29 | 30 | sbb43 | 100 | 1300 | 1680 |
| Bjh1906 in AK | 31 | 32 | Bjh1906 | 47 | 1247 | 1680 |
| sbb14 in KC | 33 | 34 | sbb14 | 1845 | 2911 | 1605 |
| sbb13 in KC | 35 | 36 | sbb13 | 1818 | 2884 | 1605 |
| sbb07 in KC | 37 | 38 | sbb07 | 1431 | 2497 | 1605 |
| Bjh1906 in CA | 39 | 40 | Bjh1906 | 47 | 1319 | 1473 |
| sbb18 in CA | 41 | 42 | sbb18 | 399 | 1671 | 1473 |
| sbb44 in CA | 43 | 44 | sbb44 | 823 | 2095 | 1473 |
| sbb42 in CA | 45 | 46 | sbb42 | 91 | 1363 | 1473 |
| ig114 in CA | 47 | 48 | ig114 | 1244 | 2516 | 1473 |
| ' | Part A Lane # | Part B Lane # | Part Name | Part size | Eco/xho Frags | eco/Xho Frags |
| sbb43 in AC | 1 | 2 | sbb43 | 100 | 1166 | 1679 |
| sbb13 in AC | 3 | 4 | sbb13 | 1818 | 2884 | 1679 |
| sbb20 in AC | 5 | 6 | sbb20 | 597 | 1663 | 1679 |
| sbb06 in KA | 7 | 8 | sbb06 | 241 | 1513 | 1605 |
| sbb04 in KA | 9 | 10 | sbb04 | 1788 | 3060 | 1605 |
| Bjh2245 in KA | 11 | 12 | Bjh2245 | 97 | 1369 | 1605 |
| sbb16 in CK | 13 | 14 | sbb16 | 90 | 1290 | 1473 |
| Bjh1858 in CK | 15 | 16 | Bjh1858 | 33 | 1233 | 1473 |
| Bjh1906 in KA | 17 | 18 | Bjh1906 | 47 | 1319 | 1605 |
| sbb19 in KA | 19 | 20 | sbb19 | 597 | 1869 | 1605 |
| sbb12 in KA | 21 | 22 | sbb12 | 234 | 1506 | 1605 |
| sbb09 in KA | 23 | 24 | sbb09 | 35 | 1307 | 1605 |
| sbb10 in KA | 25 | 26 | sbb10 | 1026 | 2298 | 1605 |
| sbb42 in KA | 27 | 28 | sbb42 | 91 | 1363 | 1605 |
| Bjh2294 in KA | 29 | 30 | Bjh2294 | 2507 | 3779 | 1605 |
| sbb07 in KA | 31 | 32 | sbb07 | 1431 | 2703 | 1605 |
| sbb18 in AK | 33 | 34 | sbb18 | 399 | 1599 | 1680 |
| sbb17 in AK | 35 | 36 | sbb17 | 399 | 1599 | 1680 |
| sbb12 in AK | 37 | 38 | sbb12 | 234 | 1434 | 1680 |
| sbb09 in AK | 39 | 40 | sbb09 | 35 | 1235 | 1680 |
| sbb42 in AK | 41 | 42 | sbb42 | 91 | 1291 | 1680 |
| Bjh2294 in AK | 43 | 44 | Bjh2294 | 2507 | 3707 | 1680 |
| sbb06 in AK | 45 | 46 | sbb06 | 241 | 1441 | 1680 |
| sbb20 in AK | 47 | 48 | sbb20 | 597 | 1797 | 1680 |
| ' | Part A Lane # | Part B Lane # | Part Name | Part size | Eco/xho Frags | eco/Xho Frags |
| sbb08 in KC | 1 | 2 | sbb08 | 35 | 1101 | 1605 |
| sbb11 in KC | 3 | 4 | sbb11 | 232 | 1298 | 1605 |
| sbb05 in KC | 5 | 6 | sbb05 | 319 | 1385 | 1605 |
| Bjh1858 in CA | 7 | 8 | Bjh1858 | 33 | 1305 | 1473 |
Christoph Neyer 20:18, 2 July 2010 (EDT)
Decided to redo all the methylations.
Christoph Neyer 18:40, 29 June 2010 (EDT)
Restriction digest of iGEM10_76 (clones 2-6). Expect bands at ~3100 and ~1700:

Christoph Neyer 19:03, 28 June 2010 (EDT)
Colony PCR of manually assembled parts iGEM10_076-79:

Christoph Neyer 17:45, 28 June 2010 (EDT)
Restriction map of catchup methylated parts:

Layout:
| Part | Strain | Clone number | Part number | ' | Lane Number | Part size | eco/xho frags | eco/xho frags |
| 8 with 1 | R | 4 | 1 | 1 | 35 | 1307 | 1473 | |
| 9 with 3 | R | 4 | 3 | 2 | 33 | 1099 | 1605 | |
| 8 with 1 | R | 3 | 1 | 3 | 35 | 1307 | 1473 | |
| 9 with 3 | R | 3 | 3 | 4 | 33 | 1099 | 1605 | |
| 8 with 1 | R | 2 | 1 | 5 | 35 | 1307 | 1473 | |
| 9 with 3 | R | 2 | 3 | 6 | 33 | 1099 | 1605 | |
| 8 with 1 | R | 1 | 1 | 7 | 35 | 1307 | 1473 | |
| 9 with 3 | R | 1 | 3 | 8 | 33 | 1099 | 1605 | |
| -- | -- | -- | ||||||
| 9 with 23 | L | 4 | 23 | 9 | 91 | 1157 | 1605 | |
| 5 with 20 | L | 4 | 20 | 10 | 823 | 2023 | 1473 | |
| 9 with 23 | L | 3 | 23 | 11 | 91 | 1157 | 1605 | |
| 5 with 20 | L | 3 | 20 | 12 | 823 | 2023 | 1473 | |
| 9 with 23 | L | 2 | 23 | 13 | 91 | 1157 | 1605 | |
| 5 with 20 | L | 2 | 20 | 14 | 823 | 2023 | 1473 | |
| 9 with 23 | L | 1 | 23 | 15 | 91 | 1157 | 1605 | |
| 5 with 20 | L | 1 | 20 | 16 | 823 | 2023 | 1473 | |
| Ladder | -- | |||||||
| 9 with 11 | L | 4 | 11 | 17 | 46 | 1112 | 1605 | |
| 8 with 21 | R | B1 | 21 | 18 | 232 | 1504 | 1473 | |
| 9 with 11 | L | 3 | 11 | 19 | 46 | 1112 | 1605 | |
| 8 with 21 | R | B2 | 21 | 20 | 232 | 1504 | 1473 | |
| 9 with 11 | L | 2 | 11 | 21 | 46 | 1112 | 1605 | |
| 8 with 21 | R | B3 | 21 | 22 | 232 | 1504 | 1473 | |
| 9 with 11 | L | 1 | 11 | 23 | 46 | 1112 | 1605 | |
| 8 with 21 | R | B4 | 21 | 24 | 232 | 1504 | 1473 | |
| -- | -- | -- | ||||||
| 9 with 20 | L | 4 | 20 | 25 | 823 | 1889 | 1605 | |
| 8 with 21 | R | A1 | 21 | 26 | 232 | 1504 | 1473 | |
| 9 with 20 | L | 3 | 20 | 27 | 823 | 1889 | 1605 | |
| 8 with 21 | R | A2 | 21 | 28 | 232 | 1504 | 1473 | |
| 9 with 20 | L | 2 | 20 | 29 | 823 | 1889 | 1605 | |
| 8 with 21 | R | A3 | 21 | 30 | 232 | 1504 | 1473 | |
| 9 with 20 | L | 1 | 20 | 31 | 823 | 1889 | 1605 | |
| 8 with 21 | R | A4 | 21 | 32 | 232 | 1504 | 1473 | |
Christoph Neyer 19:41, 25 June 2010 (EDT)
Made methylated basic parts and plated. Need to take out of incubator on Saturday.
Did manual 2ab test run for:
- iGEM10_076
- iGEM10_077
- iGEM10_078
- iGEM10_079
Plated on a strip today with four different volumes (20,30,40,50ul).
TO DO:
- Need to double check 7 w/ 10 Lefty from plate A. Looked like it didn't get digested.
- Need to colony PCR basic parts and composite parts on Monday and then minprep and restriction map for assembly on Tuesday.
Christoph Neyer 19:41, 25 June 2010 (EDT)
Made methylated basic parts and plated. Need to take out of incubator on Saturday.
Did manual 2ab test run for:
- iGEM10_076
- iGEM10_077
- iGEM10_078
- iGEM10_079
Plated on a strip today with four different volumes (20,30,40,50ul).
TO DO:
- Need to double check 7 w/ 10 Lefty from plate A. Looked like it didn't get digested.
- Need to colony PCR basic parts and composite parts on Monday and then minprep and restriction map for assembly on Tuesday.
Christoph Neyer 21:13, 24 June 2010 (EDT)
TO DO:
- Make methylated basic parts:
- 9 with 11
- 5 with 20
- 9 with 20
- 9 with 23
- 8 with 1
- 8 with 21
- 9 with 3
- Manual 2ab test run for two junctions (4 basic parts -> 2 composite parts):
- iGEM10_065
- iGEM10_071
- Create methylated plate layout and transfer parts to it.
- Once methylated plate is made restriction map it and sequence a few.
Christoph Neyer 17:54, 24 June 2010 (EDT)
Restricton map of methylated parts from plate A:

Layout of parts from plate A:
| Parts from plate A | ' | ' | ' | ' | ' |
| Plasmid | Part number | Part Size | Eco/Xho Frags | Eco/Xho Frags | Lane # |
| 5 with 20 | 20 | 823 | 2023 | 1473 | 1 |
| 5 with 25 | 25 | 41 | 1241 | 1473 | 2 |
| 9 with 11 | 11 | 46 | 1112 | 1605 | 3 |
| 9 with 20 | 20 | 823 | 1889 | 1605 | 4 |
| 9 with 23 | 23 | 91 | 1157 | 1605 | 5 |
| 7 with 10 | 10 | 100 | 1300 | 1680 | 6 |
| 5 with 15 | 15 | 90 | 1290 | 1473 | 7 |
| 5 with 3 | 3 | 33 | 1233 | 1473 | 8 |
| 8 with 1 | 1 | 35 | 1307 | 1473 | 9 |
| 8 with 21 | 21 | 232 | 1504 | 1473 | 10 |
| 4 with 10 | 10 | 100 | 1166 | 1679 | 11 |
| 4 with 18 | 18 | 1818 | 2884 | 1679 | 12 |
| 4 with 9 | 9 | 597 | 1663 | 1679 | 13 |
| 9 with 3 | 3 | 33 | 1099 | 1605 | 14 |
| Ladder | |||||
| 6 with 11 | 11 | 46 | 1318 | 1605 | 15 |
| 7 with 13 | 13 | 399 | 1599 | 1680 | 16 |
| 6 with 12 | 12 | 597 | 1869 | 1605 | 17 |
| 7 with 14 | 14 | 399 | 1599 | 1680 | 18 |
| 6 with 19 | 19 | 228 | 1500 | 1605 | 19 |
| 7 with 19 | 19 | 228 | 1428 | 1680 | 20 |
| 6 with 2 | 2 | 35 | 1307 | 1605 | 21 |
| 7 with 2 | 2 | 35 | 1235 | 1680 | 22 |
| 6 with 22 | 22 | 1026 | 2298 | 1605 | 23 |
| 7 with 23 | 23 | 91 | 1291 | 1680 | 24 |
| 6 with 23 | 23 | 91 | 1363 | 1605 | 25 |
| 7 with 24 | 24 | 2400 | 3600 | 1680 | 26 |
| 6 with 24 | 24 | 2400 | 3672 | 1605 | 27 |
| 7 with 5 | 5 | 241 | 1441 | 1680 | 28 |
| 6 with 4 | 4 | 1431 | 2703 | 1605 | 29 |
| 7 with 9 | 9 | 597 | 1797 | 1680 | 30 |
Col PCR map of basic parts:

Layout of ColPCR:
| Plasmid | Part number | Part Size | Eco/Xho Frags | Eco/Xho Frags | Lane # |
| 5 with Bca1091 | Bca1091 | 60 | 1260 | 1473 | 1 |
| 6 with Bjh2245 | Bjh2245 | 97 | 1369 | 1605 | 2 |
| 6 with 12 | 12 | 597 | 1869 | 1605 | 3 |
| 5 with 25 | 25 | 41 | 1241 | 1473 | 4 |
| 9 with 11 | 11 | 46 | 1112 | 1605 | 5 |
| 9 with 23 | 23 | 91 | 1157 | 1605 | 6 |
Christoph Neyer 20:41, 23 June 2010 (EDT)
Restriction map of methylated parts Plate B:
Part 1:

Part 2:

Layout:
| ' | RE mapping of ALL methylated parts, Plate B | RE mapping plate layout: | ' | ' | ' |
| Ladder | |||||
| 4 with 16 | 16 | 90 | 1156 | 1679 | 1 |
| 5 with 20 | 20 | 823 | 2023 | 1473 | 2 |
| 4 with 17 | 17 | 1845 | 2911 | 1679 | 3 |
| 5 with 23 | 23 | 91 | 1291 | 1473 | 4 |
| 4 with Bjh1882 | Bjh1882 | 681 | 1747 | 1679 | 5 |
| 5 with 25 | 25 | 41 | 1241 | 1473 | 6 |
| 9 with 11 | 11 | 46 | 1112 | 1605 | 7 |
| 5 with 3 | 3 | 33 | 1233 | 1473 | 8 |
| 9 with 13 | 13 | 399 | 1465 | 1605 | 9 |
| 5 with 8 | 8 | 1244 | 2444 | 1473 | 10 |
| 9 with 20 | 20 | 823 | 1889 | 1605 | 11 |
| 5 with Bca1091 | Bca1091 | 60 | 1260 | 1473 | 12 |
| 9 with 23 | 23 | 91 | 1157 | 1605 | 13 |
| 8 with 17 | 17 | 1845 | 3117 | 1473 | 14 |
| 9 with 8 | 8 | 1244 | 2310 | 1605 | 15 |
| 8 with 18 | 18 | 1818 | 3090 | 1473 | 16 |
| Ladder | |||||
| 6 with 12 | 12 | 597 | 1869 | 1605 | 17 |
| 7 with 13 | 13 | 399 | 1599 | 1680 | 18 |
| 6 with 13 | 13 | 399 | 1671 | 1605 | 19 |
| 7 with 14 | 14 | 399 | 1599 | 1680 | 20 |
| 6 with 22 | 22 | 1026 | 2298 | 1605 | 21 |
| 7 with 19 | 19 | 228 | 1428 | 1680 | 22 |
| 6 with 23 | 23 | 91 | 1363 | 1605 | 23 |
| 7 with 2 | 2 | 35 | 1235 | 1680 | 24 |
| 6 with 7 | 7 | 1788 | 3060 | 1605 | 25 |
| 7 with 23 | 23 | 91 | 1291 | 1680 | 26 |
| 7 with 10 | 10 | 100 | 1300 | 1680 | 27 |
| 7 with 24 | 24 | 2400 | 3600 | 1680 | 28 |
| 7 with 11 | 11 | 46 | 1246 | 1680 | 29 |
| 7 with 5 | 5 | 241 | 1441 | 1680 | 30 |
| 8 with 4 | 4 | 1431 | 2703 | 1473 | 31 |
| 7 with 9 | 9 | 597 | 1797 | 1680 | 32 |
| Ladder | |||||
| 6 with 11 | 11 | 46 | 1318 | 1605 | 33 |
| 5 with 15 | 15 | 90 | 1290 | 1473 | 34 |
| 6 with 12 | 12 | 597 | 1869 | 1605 | 35 |
| 5 with 3 | 3 | 33 | 1233 | 1473 | 36 |
| 6 with 19 | 19 | 228 | 1500 | 1605 | 37 |
| 8 with 1 | 1 | 35 | 1307 | 1473 | 38 |
| 6 with 2 | 2 | 35 | 1307 | 1605 | 39 |
| 8 with 21 | 21 | 232 | 1504 | 1473 | 40 |
| 6 with 22 | 22 | 1026 | 2298 | 1605 | 41 |
| 8 with 6 | 6 | 319 | 1591 | 1473 | 42 |
| 6 with 23 | 23 | 91 | 1363 | 1605 | 43 |
| 6 with 5 | 5 | 241 | 1513 | 1605 | 44 |
| 6 with 24 | 24 | 2400 | 3672 | 1605 | 45 |
| 6 with 7 | 7 | 1788 | 3060 | 1605 | 46 |
| 6 with 4 | 4 | 1431 | 2703 | 1605 | 47 |
| 6 with Bjh2245 | 15 | 90 | 1362 | 1605 | 48 |
| Ladder | |||||
| Gel #2 | |||||
| Ladder | |||||
| 4 with 10 | 10 | 100 | 1166 | 1679 | 1 |
| 4 with 18 | 3 | 33 | 1099 | 1679 | 2 |
| 4 with 9 | 18 | 1818 | 2884 | 1679 | 3 |
| 9 with 3 | 1 | 35 | 1101 | 1605 | 4 |
| 6 with 24 | 24 | 2400 | 3672 | 1605 | 5 |
| 7 with 23 | 23 | 91 | 1291 | 1680 | 6 |
| 7 with 24 | 24 | 2400 | 3600 | 1680 | 7 |
| 9 with 11 | 11 | 46 | 1112 | 1605 | 8 |
| 9 with 23 | 23 | 91 | 1157 | 1605 | 9 |
| 5 with Bca1091 | Bca1091 | 60 | 1260 | 1473 | 10 |
| 4 with Bjh1882 | Bjh1882 | 681 | 1747 | 1679 | 11 |
| 6 with Bjh2245 | Bjh2245 | 97 | 1369 | 1605 | 12 |
| 6 with 12 | 12 | 597 | 1869 | 1605 | 13 |
| 5 with 25 | 25 | 41 | 1241 | 1473 | 14 |
Christoph Neyer 17:44, 23 June 2010 (EDT)
Restriction map of unmethylated parts:
Christoph Neyer 13:06, 23 June 2010 (EDT)
Restriction Map of methylated parts plate rows A and E:

Layout:
| ' | Part number | Part Size | Eco/Xho Frags | Eco/Xho Frags | Lane # |
| 4 with 16 | 16 | 90 | 1066 | 1769 | 1 |
| 9 with 13 | 13 | 399 | 1066 | 2004 | 2 |
| 5 with 20 | 20 | 823 | 1200 | 2296 | 3 |
| 5 with 8 | 8 | 1244 | 1200 | 2717 | 4 |
| 6 with 12 | 12 | 597 | 1272 | 2202 | 5 |
| 6 with 7 | 7 | 1788 | 1272 | 3393 | 6 |
| 7 with 13 | 13 | 399 | 1200 | 2079 | 7 |
| 7 with 23 | 23 | 91 | 1200 | 1771 | 8 |
| 6 with 11 | 11 | 46 | 1272 | 1651 | 9 |
| 6 with 22 | 22 | 1026 | 1272 | 2631 | 10 |
| 5 with 15 | 15 | 90 | 1200 | 1563 | 11 |
| 8 with 6 | 6 | 319 | 1272 | 1792 | 12 |
| 4 with 10 | 10 | 100 | 1066 | 1779 | 13 |
Christoph Neyer 13:16, 22 June 2010 (EDT)
Restriction Map Rerun:

Layout:
| Restriction Mapping | ' | Lane #s A | B | Part size | eco/xho frags | eco/xho frags |
| 9 with iGEM10_023 | R | 1 | 2 | 1879 | 2945 | 1605 |
| 9 with iGEM10_024 | R | 3 | 4 | 1522 | 2588 | 1605 |
| 9 with iGEM10_028 | L | 5 | 6 | 157 | 1223 | 1605 |
| 9 with iGEM10_025 | R | 7 | 8 | 323 | 1389 | 1605 |
| 9 with iGEM10_027 | L | 9 | 10 | 858 | 1924 | 1605 |
| 8 with iGEM10_029 | L | 11 | 12 | 1909 | 3181 | 1473 |
| 9 with iGEM10_034 | R2 | 13 | 14 | 1064 | 2130 | 1605 |
| 5 with iGEM10_035 | R | 15 | 16 | 996 | 2196 | 1473 |
| 7 with iGEM10_040 | R | 17 | 18 | 771 | 1971 | 1680 |
| 9 with iGEM10_008 | R | 19 | 20 | 1057 | 2123 | 1605 |
| 6 with iGEM10_033 | L | 21 | 22 | 1464 | 2736 | 1605 |
Daniela Mehech 14:19, 21 June 2010 (EDT)
Colony PCR results from Group 2
lane 1,3,5,7 = 5 w/ 35 L
lane 2,4,6,8 = 5 w/ 38
lane 9,11,13,15 = 5 w/ 35 R
lane 10,12,14,16 = 6 w/33 L
lane 17,19,21,23 = 6 w/33 R
lane 18,20,22,24 = 9 w/ 8 L
lane 25, 27,29,31 = 7 w/40
lane 26,28,30,32 = 9 w/ 34 L
lane 33,34,35,36 = 9 w/ 8 R
lane 37,38,39,40 = 9 w/ 34 R
Except for first 8 lanes, everything looked good and we mini-prepped two of each. Mini-prepped lanes 1-8 too and will send them for sequencing
Colony PCR results for group 3:
Loaded as: 1,9,2,10,3,11,4,12,5,13,6,14,7,15,8,16,17,25,18,26,19,27,20,28,21,29,22,30,23,31,24,32
Colony PCR results for group 4:
Restriction Mapping of everything we've mini-prepped (groups 1 and 2)
Right Half
Left Half
To Do
Check for co-transformation for Groups 3 and 4
Mini-Prep good colonies of group 3 and 4
Send to sequencing some parts?
Begin Stage 2 (hopefully all our stage 1 parts are right)
Daniela Mehech 21:28, 18 June 2010 (EDT)
We labeled our transformation plate wrong so when we went to plate the cells many of them were plated on the wrong antibiotics. We still had colonies grow because they were co-transformed and had resistance to all antibiotics. This also explains why so many colonies grew when we tested for co-transformation. We have split our stage 1 parts into 4 groups:
1. Colonies grew on proper antibiotics and were not co-transformed. There are 12 of these. We mini-prepped these today and will do restriction mapping properly on Monday
2. Colonies that grew on wrong antibiotics need to be redone. There are 10 of these.We digested, ligated and transformed them today.
3. Parts that we thought we hadn't done (see yesterday's notes), but it turns out we did do them without realizing it since our plates were labeled wrong. Since we did them twice and they were all plated correctly the second time we will pick colonies, do Colony PCR, check for co-transformation and mini-prep these 9 on Monday.
4. Colonies that grew on the right antibiotics but were co-transformed. We will pick more colonies from the original plate to do ColPCR
Daniela Mehech 18:37, 17 June 2010 (EDT)
We got cell growth for every part we plated (although in some parts there were very few colonies, about 3 or 4).
We made a Colony PCR Mastermix and tried to distribute it to two PCR plates with the robot but the robot kept giving us an error message (It said it couldn't pipette 19uL if there was 17uL in the tube but there was 2 ml in the tube and we wanted it to pipette 17uL). We gave up and I pipetted all 136 wells by hand.
Christoph and I picked colonies, added them to the PCR plate, innoculated them in a 96-well plate and left them in the incubator. We ran a ColPCR3K program on the both PCR plates.
Christoph noticed that we had based all of our csv robot files from the wrong list. We made all of the parts we needed but some of the parts had to be inserted into multiple vector backbones. We began making the 6 forgotten parts by hand. 3 of these parts need to be transformed into both Righties and Lefties so we're making 9 parts by hand.
We dabbed broth from our 96-well inoculated plate on both AKC plates and LB-only plates as negative and positive controls respectively for whether we picked any co-transformed colonies.
We need to run a huge gel when the PCR finishes at 4:40pm. Then we need to analyze the results. Christoph already named all the new composite parts and calculated their sizes.
To Do
We will mini-prep our good colonies tomorrow. Hopefully we'll have at least two good copies for each part so that we can continue with Plates A and B for stage 2.
We can start planning for Stage 2 assembly when we have free time. If we do it beforehand hopefully we'll catch any mistakes before running the robot
We should make a list of all the information Clothos gives us after it solves for the assembly tree. We've had to spent a good chunk of time writing excel formulas and making spreadsheets just so we know exactly how to assemble everything
Christoph Neyer 21:26, 18 June 2010 (EDT)
Did Eco/Bam digest of good parts and here is the layout on the gel:
After about 20mins:


| ' | ' | ' | ' | ' | Lane # | ' |
| part size +200 | Eco/Bam frags | Eco/Bam frags | A | B | ||
| 7 with iGEM10_022 | R | 2078 | 4755 | 4755 | 1 | 2 |
| 9 with iGEM10_023 | R | 2079 | 4624 | 4624 | 3 | 4 |
| 9 with iGEM10_024 | R | 1722 | 4267 | 4267 | 5 | 6 |
| 9 with iGEM10_028 | L | 357 | 157 | 2745 | 7 | 8 |
| 4 with iGEM10_036 | R | 282 | 2827 | 2827 | 9 | 10 |
| 4 with iGEM10_037 | R | 566 | 3111 | 3111 | 11 | 12 |
| 4 with iGEM10_009 | R | 479 | 3024 | 3024 | 13 | 14 |
| 9 with iGEM10_025 | R | 523 | 3068 | 3068 | 15 | 16 |
| 9 with iGEM10_027 | L | 1058 | 858 | 2745 | 17 | 18 |
| 8 with iGEM10_029 | L | 2109 | 1909 | 2671 | 19 | 20 |
| 9 with iGEM10_026 | L | 1535 | 1335 | 2745 | 21 | 22 |
| 9 with iGEM10_027 | R | 1058 | 3603 | 3603 | 23 | 24 |
Christoph Neyer 15:51, 18 June 2010 (EDT)
Found out that we mixed up some things while creating the plate layouts for stage1 and we ended up plating on the wrong antibiotics.
- We need to spot check and colony PCR the catchups we started yesterday. (9 total):
| Name | Strain | Lefty Input | Righty Input |
| 5 with iGEM10_026 | L | 9 with 8 | 7 with 23 |
| 5 with iGEM10_027 | L | 9 with 20 | 7 with 2 |
| 5 with iGEM10_032 | L | 9 with 23 | 7 with 13 |
| 5 with iGEM10_034 | L | 9 with 20 | 7 with 5 |
| 5 with iGEM10_008 | L | 9 with 20 | 7 with 19 |
| 8 with iGEM10_035 | L | 6 with 13 | 4 with 9 |
| 5 with iGEM10_034 | R | 9 with 20 | 7 with 5 |
| 5 with iGEM10_008 | R | 9 with 20 | 7 with 19 |
| 8 with iGEM10_035 | R | 6 with 13 | 4 with 9 |
- Assembled these parts that we missed/plated on the wrong antibiotics manually:
| Name | Strain | Lefty Input | Righty Input |
| 5 with iGEM10_035 | L | 9 with 13 | 7 with 9 |
| 6 with iGEM10_033 | L | 8 with 4 | 9 with 3 |
| 9 with iGEM10_034 | L | 5 with 20 | 6 with 5 |
| 9 with iGEM10_008 | L | 5 with 20 | 6 with 19 |
| 5 with iGEM10_035 | L | 9 with 13 | 7 with 9 |
| 5 with iGEM10_038 | R | 9 with 11 | 7 with 24 |
| 7 with iGEM10_040 | R | 4 with Bjh1882 | 5 with 15 |
| 6 with iGEM10_033 | R | 8 with 4 | 9 with 3 |
| 9 with iGEM10_034 | R | 5 with 20 | 6 with 5 |
| 9 with iGEM10_008 | R | 5 with 20 | 6 with 19 |
| 5 with iGEM10_035 | R | 9 with 13 | 7 with 9 |
Christoph Neyer 13:30, 18 June 2010 (EDT)
We spot checked our colony PCR colonies on ACK to check for co-transformation and this is what our plates look like:
Plate A
Christoph Neyer 21:22, 17 June 2010 (EDT)
Colony PCR results for Stage1 parts:
Here are columns 1-6 in two parts:
Part 1 (Parts 1 and 2 are picutres of the same gels)

and Part 2

Here are columns 7-10:

Christoph Neyer 18:24, 17 June 2010 (EDT)
Most of the colonies turned out good for Stage 1 of the robot assembly. We picked colonies for colony PCR.
Manually made these parts for Stage 1 using the robot protocol. We missed them some how:
| Name | Strain | Lefty Input | Righty Input |
| 5 with iGEM10_026 | L | 9 with 8 | 7 with 23 |
| 5 with iGEM10_027 | L | 9 with 20 | 7 with 2 |
| 5 with iGEM10_032 | L | 9 with 23 | 7 with 13 |
| 5 with iGEM10_034 | L | 9 with 20 | 7 with 5 |
| 5 with iGEM10_008 | L | 9 with 20 | 7 with 19 |
| 8 with iGEM10_035 | L | 6 with 13 | 4 with 9 |
| 5 with iGEM10_034 | R | 9 with 20 | 7 with 5 |
| 5 with iGEM10_008 | R | 9 with 20 | 7 with 19 |
| 8 with iGEM10_035 | R | 6 with 13 | 4 with 9 |
Christoph Neyer 21:15, 16 June 2010 (EDT)
While plating Stage1 2ab assembly set A we may have reversed the order of Col 1 B (30 ul).
The cells from plate A3-D3 may be in wells B4-B1 instead of B1-B4 on the 2x12 plated for Col 1A from the reaction plate.
Also note rows A and B were switched on the plate for Col 5A as noted on the plate. A is 30ul and B is 60ul instead of the other way around.
Christoph Neyer 18:10, 16 June 2010 (EDT)
Redoing Stage1B and doing Stage1A 2ab assembly today.
Check autoclave at 4:30.
Decided to redo all of B along with A. We can do them together on the robot by doubling everything but changing the source plate
Made dilution plate A, and added 60uL of dilution to dilution plate B. 7 with 11 still looked different
Distributed digestion cocktail to both dilution plates Note: Robot begins pipetting air if it uses the same tip for two long. We stopped the program halfway through to change its tip Distributed Righty and Lefty parts to reaction plates. Made sure there were duplicate columns for parts being transformed twice Checked that at this point all wells had the same volume Put plates in thermocycler to incubate and heat kill Distributed antibiotics to 10 plates. All of LB agar was contaminated so will pour that during the rescue step added ligation mixture to each well and let incubate at room temperature.
Christoph Neyer 18:11, 16 June 2010 (EDT)
Robot 2AB assembly Stage 1
Yesterday we did stage 1 of our 2AB assembly only on plate B. Today we will repeat the process on plate A without making all of the mistakes that we did yesterday.
June 15:
Autoclaved our strips for plating. Learned how to work the autoclave machine
Made a new plate layout for the reaction plate. Wells are organized by what strain the part needs to be transformed into to
MISTAKE: Did not listen to Tim and organized wells by column instead of rows. Rows are better because the plating strips have 2 rows and 12 columns
MISTAKE: Did not read procedure all the way through in detail and assumed that we could use a well for two transformations. Our dilution and reaction plate needs to have duplicates of the parts that go into both Righty and Lefty strains. We have to add the duplicates in either the dilution or reaction plate
Made the dilution plate B (30ul of DNA into each well + 30ul of NEB2 stock diluted by a factor of 5). Dilution plate had the same layout as methylated stock plate so we did it by hand. Next time, we should consider adding duplicates of the parts being transformed twice.
NOTE: 7 with 11 was frozen in our methylated stocks plate. This is the part that was mini-prepped separately the day before. All other wells weren't frozen.
Had the robot make reaction plate (distribute digestion mastermix to all wells, distribute all Lefty parts, mix, distribute all righty parts, mix)
While the reaction plate incubated in the black thermocycler (which also did heat kill of the digestion enzymes) we distributed the antibiotics to the 24-well strips. We made antibiotics (dilute stock by 10, add 1ul of dye). This part went fine except we should have labeled the plates before we put them on the robot. Added LB agar to the plates and let them dry next to the flame.
MISTAKE: forgot to make second plate for parts being transformed twice. Column 5 in reaction plate needed to go to two different plates. We made the extra plate by hand
Had robot add the ligation cocktail to the wells and let it incubate at room temperature. We began thawing our bacteria.
Did transformation of bacteria. We had enough volume to seed at least 60uL of bacteria per column.
MISTAKE: Did not realize that the protocol was for seeding 10uL of bacteria. We wanted to seed about 150uL. We should not have done the centrifugation and aspiration of the supernatant step.
MISTAKE: ejecting tips from multi-channel before releasing cells on plate. We lost 60uL of our cells from column 7.
MISTAKE: We split the volume in column 5 into column 9 (because column 5 had to be transformed into both righty and lefty strains). Thus we also did not have enough volume for those parts.
MISTAKE: not taking a short break after lunch to re-energize and prevent making silly mistakes
Christoph Neyer 20:10, 15 June 2010 (EDT)
- Reorganize destination plate based on L and R not on antibiotics. CHECK
- AUTOCLAVE 24 well Strips! CHECK
- Digesting (1hr) Check
- Dilute NEB2 and DNA.
- Make plates (2hr) Check
- Cherry pick antibiotics Check
- Heat kill (20 mins)Check
- Ligation (30 mins)Check
- Transform + Rescuing (1hr) Check
- Plate (1hr)Check
Forgot to make two copies of the parts that are both lefty and righty. So, we just used half of ligation product of each.
Here is the layout of the transformation plate:

Column 5 is Lefty and was transformed with only half the ligation product.
Column 9 is righty and was also transformed with half the ligation product.
Christoph Neyer 21:29, 14 June 2010 (EDT)
Goal for tomorrow is to transform and plate stage 1A and 1B. That involves:
- Reorganize destination plate based on L and R not on antibiotics.
- AUTOCLAVE 24 well Strips!
- Digesting (1hr)
- Dilute NEB2 and DNA.
- Make plates (2hr)
- Cherry pick antibiotics
- Heat kill (20 mins)
- Ligation (30 mins)
- Transform + Rescuing (1hr)
- Plate (1hr)
Christoph Neyer 14:18, 14 June 2010 (EDT)
Thanks to Tim and Shelly for picking colonies from methylation transformation
- May have mislabeled these tubes, so we are running a BglII/Xho map:
Put in digest at 11am. Run gel at 11:30.

Looks ok. Added these parts to methylated parts plates
| Lane # | ID | Name | Expected fragments | ' |
| 1 | 4 with 10 #1 | pMLL4-AC+B10sbb43 | 850 | 1990 |
| 2 | 4 with 10 #2 | pMLL4-AC+B10sbb43 | 850 | 1990 |
| 3 | 4 with 18 #1 | pMLL4-AC+B10sbb13 | 850 | 2160 |
| 4 | 4 with 18 #2 | pMLL4-AC+B10sbb13 | 850 | 2160 |
| 5 | 4 with 9 #1 | pMLL4-AC+B10Sbb20 | 850 | 2450 |
| 6 | 4 with 9 #2 | pMLL4-AC+B10Sbb20 | 850 | 2450 |
| 7 | 9 with 3 #1 | pMLL9-CA+Bjh1853 | 300 | 1500 |
| 8 | 9 with 3 #2 | pMLL9-CA+Bjh1853 | 300 | 1500 |
Christoph Neyer 21:36, 11 June 2010 (EDT)
Plated Transformations from robot dilution.
Christoph Neyer 19:04, 11 June 2010 (EDT)
Next step is to transform each part into a Righty or Lefty strain.
Manually transformed parts from dilution plate into Righty and Lefty strains. Incubated at 5:10. Take out at 5:50.
Transformation plate has same layout as dilution plate below. Here is layout again:
Transformation plate layout
Columns 1-6 are in Righty strains. Columns 7-12 are in Lefty strains.
| ' | 1 | 2 | 3 | 4 | 5 | 6 | 7 | 8 | 9 | 10 | 11 | 12 |
| A | 4 with 16 | 5 with 20 | 6 with 12 | 7 with 10 | 8 with 17 | 9 with 11 | 4 with 10 | 6 with 11 | 6 with 5 | 7 with 13 | 8 with 1 | 9 with 3 |
| B | 4 with 17 | 5 with 23 | 6 with 13 | 7 with 11 | 8 with 18 | 9 with 13 | 4 with 18 | 6 with 12 | 6 with 7 | 7 with 14 | 8 with 21 | |
| C | 4 with Bjh1882 | 5 with 25 | 6 with 22 | 8 with 4 | 9 with 20 | 4 with 9 | 6 with 19 | 6 with Bjh2245 | 7 with 19 | 8 with 6 | ||
| D | 5 with 3 | 6 with 23 | 9 with 23 | 6 with 2 | 7 with 2 | |||||||
| E | 5 with 8 | 6 with 7 | 9 with 8 | 6 with 22 | 7 with 23 | |||||||
| F | 6 with Bca1091 | 6 with 23 | 7 with 24 | |||||||||
| G | 5 with 15 | 6 with 24 | 7 with 5 | |||||||||
| H | 5 with 3 | 6 with 4 | 7 with 9 | |||||||||
Christoph Neyer 16:31, 11 June 2010 (EDT)
Did a test run with the robot using our dilution csv file. Checked cloumn 4 it worked well.
Miniprepped pMLL5+Bca1152 and sent in for sequencing as iGem021.
Using robot to dilute 4ul of each vector+part stage 0 assembly into 76ul of water. See this csv file: Media:Stage0PartsDilution.csv
Source plate layout:
| ' | 1 | 2 | 3 | 4 | 5 | 6 | 7 | 8 | 9 | 10 | 11 | 12 |
| A | 6+2 | 6+11 | 6+22 | 7+9 | 7+24 | 5+23 | 8+17 | 4+10 | 9+3 | 9+20 | 7+24 | |
| B | 6+2 | 6+11 | 6+22 | 7+10 | 5+3 | 5+23 | 8+17 | 4+10 | 9+3 | 9+20 | 9+11 | |
| C | 6+4 | 6+12 | 6+23 | 7+11 | 5+3 | 8+1 | 8+18 | 4+16 | 9+8 | 9+23 | 9+23 | |
| D | 6+4 | 6+12 | 6+23 | 7+13 | 5+8 | 8+1 | 8+18 | 4+16 | 9+8 | 9+23 | pMLL5+Bca1091 (L) | |
| E | 6+5 | 6+13 | 6+24 | 7+14 | 5+8 | 8+4 | 8+21 | 4+17 | 9+11 | pMLL4+Bjh1882 (L) | ||
| F | 6+5 | 6+13 | 6+24 | 7+19 | 5+15 | 8+4 | 8+21 | 4+17 | 9+11 | pMLL6+Bjh2245 | ||
| G | 6+7 | 6+19 | 7+2 | 7+23 | 5+20 | 8+6 | 4+9 | 4+18 | 9+13 | 6 +24 | 6+12 | |
| H | 6+7 | 6+19 | 7+5 | 7+24 | 5+20 | 8+6 | 4+9 | 4+18 | 9+13 | 7 + 23 | 5+25 (D) | |
Destination plate layout:
Columns 1-6 need to be transformed into Righty strains. Columns 7-12 need to be transformed into Lefty strains.
| ' | 1 | 2 | 3 | 4 | 5 | 6 | 7 | 8 | 9 | 10 | 11 | 12 |
| A | 4 with 16 | 5 with 20 | 6 with 12 | 7 with 10 | 8 with 17 | 9 with 11 | 4 with 10 | 6 with 11 | 6 with 5 | 7 with 13 | 8 with 1 | 9 with 3 |
| B | 4 with 17 | 5 with 23 | 6 with 13 | 7 with 11 | 8 with 18 | 9 with 13 | 4 with 18 | 6 with 12 | 6 with 7 | 7 with 14 | 8 with 21 | |
| C | 4 with Bjh1882 | 5 with 25 | 6 with 22 | 8 with 4 | 9 with 20 | 4 with 9 | 6 with 19 | 6 with Bjh2245 | 7 with 19 | 8 with 6 | ||
| D | 5 with 3 | 6 with 23 | 9 with 23 | 6 with 2 | 7 with 2 | |||||||
| E | 5 with 8 | 6 with 7 | 9 with 8 | 6 with 22 | 7 with 23 | |||||||
| F | 6 with Bca1091 | 6 with 23 | 7 with 24 | |||||||||
| G | 5 with 15 | 6 with 24 | 7 with 5 | |||||||||
| H | 5 with 3 | 6 with 4 | 7 with 9 | |||||||||
Christoph Neyer 13:57, 11 June 2010 (EDT)
- Added grown up Lefty and Righty strains to 500ml each of LB. Growing up for 2-3hrs. Check at 1pm.
- Running colony PCR gel for Bca1152+pMLL5. Expected band at ~260.
Colonies A,C,D look good. Chose C and D to miniprep. Cells were put in warm room at 9am.
Grab Bca1152 colony PCR colonies at 1 or 2pm.
- Added missing parts to iGEM10 plate1 minis:
| ' | 1 | 2 | 3 | 4 | 5 | 6 | 7 | 8 | 9 | 10 | 11 | 12 |
| A | 6+2 | 6+11 | 6+22 | 7+9 | 7+24 | 5+23 | 8+17 | 4+10 | 9+3 | 9+20 | 7+24 | Lysis Device |
| B | 6+2 | 6+11 | 6+22 | 7+10 | 5+3 | 5+23 | 8+17 | 4+10 | 9+3 | 9+20 | 9+11 | 5+25 |
| C | 6+4 | 6+12 | 6+23 | 7+11 | 5+3 | 8+1 | 8+18 | 4+16 | 9+8 | 9+23 | 9+23 | |
| D | 6+4 | 6+12 | 6+23 | 7+13 | 5+8 | 8+1 | 8+18 | 4+16 | 9+8 | 9+23 | pMLL5+Bca1091 (L) | |
| E | 6+5 | 6+13 | 6+24 | 7+14 | 5+8 | 8+4 | 8+21 | 4+17 | 9+11 | pMLL4+Bjh1882 (L) | ||
| F | 6+5 | 6+13 | 6+24 | 7+19 | 5+15 | 8+4 | 8+21 | 4+17 | 9+11 | pMLL6+Bjh2245 | ||
| G | 6+7 | 6+19 | 7+2 | 7+23 | 5+20 | 8+6 | 4+9 | 4+18 | 9+13 | 6 +24 | 6+12 | |
| H | 6+7 | 6+19 | 7+5 | 7+24 | 5+20 | 8+6 | 4+9 | 4+18 | 9+13 | 7 + 23 | ||
Christoph Neyer 21:03, 10 June 2010 (EDT)
TO DO:
- Pick colonies from Bca1152 and do colony PCR. Then miniprep if time.
- Play with robot
- Make competent cells.
- Transfer box parts to dilutions plate.
- When oligos arrive. Attempt biobrick on Bjh2342CA.
Christoph Neyer 13:38, 10 June 2010 (EDT)
- Had to re-grow Lefty and Righty strains since no colonies grew.
- Need to make part 5 with 25 (pMLL5-CK+B10sbb37) or (pMLL5-CK+Bca1152)
Currently in DH10B. Need to Eco/Bam transfer it into pMLL5-CK.
Put E/B digest of Bca1152 in DH10B into thermocycler at 12:10pm. Take out at 1:10pm and do small fragment zymo cleanup.
Set up ligation of Bca1152 and pMLL5 at 2:15. Transform at 2:45.
Heat-shock transformed Bca1152+pMLL5 into Jtk049. Plate at 4:15pm.
Plated Bca1152+pMLL5 into Jtk049. Growing up over night.
Sent in iGEM020 for sequencing(6 with 12C from working box to double check).
Christoph Neyer 20:31, 9 June 2010 (EDT)
TO DO List:
- Finish generating competent cells for "Lefty" and "Righty" strains.
- Analyze sequencing data for pMLL6+Bjh2245 B and C.
- Transform pMLL6+Bjh2245 into "Righty" strain.
- Transform other parts into the correct "Righty" or "Lefty" strains to prepare for robot 2ab assembly.
Christoph Neyer 15:16, 9 June 2010 (EDT)
Colony PCR of pMLL6+Bjh2245 should be at about 265bps. Looks good. Wait for colonies to grow and then miniprep.
- Sent in miniprepped pMLL4-Bjh1882 (D) and pMLL5-Bca1091 (2A) for sequencing.
- Started growing up Lefty and Righty strains. Picked two colonies of each lefty and righty and grew them up in 10ml LB.
- Designed three potential oligos for biobricking part Bjh2341CA (igemTen011, igemTen012, and igemTen013)
- Miniprepped pMLL6+Bjh2245. Need to transform into "Righty strain"
- Sent in minprepped pMLL6+Bjh2245 to be sequenced.
Christoph Neyer 13:28, 9 June 2010 (EDT)
Bca1091 is 60bps.
Colony PCR band for parts:
- pMLL4+bjh1882 = 849bps
- pMLL6+bjh2245 = 265bps
- pMLL5+bca1091 = 228bps
- For First try Colony PCR of 1882 and 1091:
- Bca1091 pick lanes 8 and 10 for miniprepping.(Block #1: Colonies from well 1D and 2A)
- For Second try Colony PCR of 1882 and 1091
- Bjh1882 pick lanes 1 and 4 for miniprepping. (Block #2: Colonies from well A and D)
Christoph Neyer 19:37, 8 June 2010 (EDT)
TO DO Tomorrow:
- Miniprep colonies that we pick for pMLL4+Bjh1882 and pMLL5+Bca1091. These are methylated correctly for the robot.
- Colony PCR pMLL6+Bjh2245 in Jtk049. These are not methylated correctly.
Christoph Neyer 19:51, 8 June 2010 (EDT)
- Ran gel of colony PCR pMLL4-Bjh1882 and pMll5-Bca1091 AGAIN:
| ladder | 1882a | b | c | d | 1901a(1) | b | c | d | ladder | 1901a(2) | b | c | d |
Christoph Neyer 16:59, 8 June 2010 (EDT)
- Ligated pMLL6 Eco/Bam digest with part Bjh2245.
- Ran gel of colony PCR pMLL4-Bjh1882 and pMll5-Bca1091:
| ladder | 1882a | b | c | d | 1901a(1) | b | c | d | ladder | 1901a(2) | b | c | d |
- Repicking colonies since Colony PCR appeared contaminated. Block has same layout, shown below:
| PCR Block 1882 and 1091 #2 | ' | ' | ' | ' |
| 1882 | 1091 #1 | 1091 #2 | ||
| A | A | A | ||
| B | B | B | ||
| C | C | C | ||
| D | D | D |
- Ran out of "Righty" cells. So we are transforming Jtk049 with our E/B ligation of pMLL6+Bjh2245.
Christoph Neyer 14:04, 8 June 2010 (EDT)
- Digested pMLL6 w/ Eco/Bam and gel purified.
- Colony PCR of transformed pMLL4-Bjh1882 and pMLL5-Bca1091:
| PCR Block 1882 and 1091 #1 | ' | ' | ' | ' |
| 1882 | 1091 #1 | 1091 #2 | ||
| A | A | A | ||
| B | B | B | ||
| C | C | C | ||
| D | D | D |
Christoph Neyer 19:30, 7 June 2010 (EDT)
Bjh1882 Vectors: AC
Bjh2245 Vectors: KA
Bca1091 Vectors: CK
pMLL4-AC
pMLL5-CK
pMLL6-KA
pMLL7-AK
pMLL8-KC
pMLL9-CA
Bjh1882+pMLL4-AC = Lefty
Bjh2245+pMLL6-KA = Righty
Bca1091+pMLL5-CK = Lefty
Ligated isolated Bjh1882 and Bca1091 into above vectors. Transformed into Lefty strains.
Need to ligate Bjh2245 (Missing pMLL6, need to digest).
TO DO:
- Digest pMLL6 with Eco/Bam and gel purify. Then ligate with Bjh2245.
- Check transformed Bjh1882 and Bca1091.
- Transform ligated Bjh2245+pMLL6 into Righty strain
Christoph Neyer 16:35, 7 June 2010 (EDT)
Couldn't see fragments. Turns out Bjh2245 is 97bp and Bjh1882 is ~680bps.
Re-cut Bjh2245 and Bjh1882.
Small fragment zymo cleanup of Bjh2245 digest.
Gel purified Bjh1882.
Christoph Neyer 15:54, 7 June 2010 (EDT)
Eco/Bam digest of parts: Bjh2245 (LifeACT), Bjh1882 (RFP), and BCA1091 (Ptet).
Gel purified Bjh1882 and Bjh2245.
Small fragment zymo cleanup of BCA1091.



























